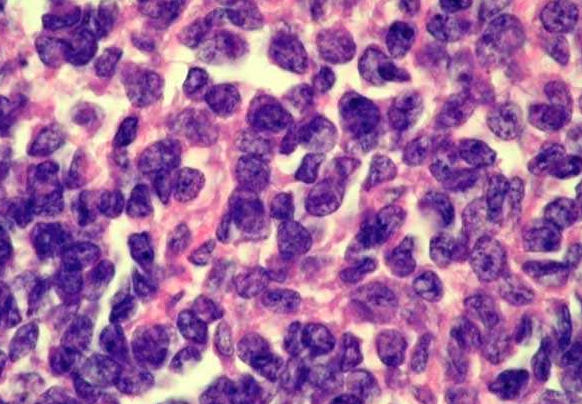

Osteosarcoma is the most common primary, malignant tumor of bone. The cancerous cells derive and from mesenchymal cells and are noted for their production of bone matrix. Osteosarcomas are associated with mutations in the retinoblastoma gene (RB) and p53. In the image, note the extensive, lace-like bone laid down by the cancerous cells. The cancerous cells vary in size and often contain very large nuclei.

Ewing’s sarcoma and primitive neuroectodermal tumor (PNET) refer to an aggressive malignant tumor involving bones and extraskeletal sites and show a characteristic t(11;22)(q24;q12) and distinct immunophenotype in most cases. The tumors usually seen between ages 5-15 years involve shafts of long bones and arise from within medullary cavity. Most cases show necrosis, at least focally (pink necrotic cells in the center), and a high mitotic rate. The solid tumor clusters are separated by fibrous bands.

[EWING’S SARCOMA/PNET, BONE] – The tumor cells are rather undifferentiated morphologically and are arranged in large sheets and clusters separated by thick fibrous bands. Necrosis may be focal or extensive (arrowhead) and may render diagnosis difficult in small biopsy specimens with few viable cells. FISH study for typical t(11;22) may prove diagnostic in smaller samples.
Ewing’s sarcoma/PNET is one of several so-called “Small blue round cell tumors.” Included among these tumors are lymphoma (especially lymphoblastic lymphoma), small cell neuroendocrine carcinomas (lung and other sites), desmoplastic small round cell tumor (abdominal and extra-abdominal), embryonal rhabdomyosarcoma, small cell variant of melanoma, and many other tumors with similar morphology. A correct diagnosis would require correlation of clinical, radiographic, morphologic, immunohistochemical, and molecular findings.

[EWING’S SARCOMA/PNET, BONE] – One of the characteristic features of ES/PNET is the presence of cytoplasmic PAS positive glycogen granules (arrowhead) which dissolves upon treatment with diastase (PAS-D). However, PAS positive cytoplasmic glycogen can be found in some cases of precursor T-cell lymphoblastic lymphoma making the differentiation difficult. In contrast to cases of ES/PNET the cytoplasmic PAS-positive granules are fewer and smaller in lymphoblastic lymphoma. However, the presence of PAS-positive cytoplasmic glycogen helps exclude small cell neuroendocrine carcinomas.

[EWING’S SARCOMA/PNET, BONE] – The neoplastic cells are small to intermediate in size with scant cytoplasm, indistinct cell membranes, round to slightly angulated nuclei containing indistinct to small nucleoli. The cells may be so undifferentiated that a morphologic distinction from any of the other small blue round cell tumors may be impossible on morphology alone. However, pseudo- rosette or true rosette formation may be present suggesting a neuroectodermal differentiation. In some tumor, however, mild pleomorphism is present with divergent immunohistochemical differentiation.

Osteosarcoma

Chondrosarcoma

Ewing sarcoma

Giant cell tumour

Aneurysmal bone cyst

Osteoblasts
Lining the trabecular bone are osteoblasts that are synthesizing bone. The initial step in bone synthesis is the formation of osteoid that consists of unmineralized collagen fibers which are produced by osteoblasts. Osteoblasts also secrete proteins and enzymes that catalyze the formation of calcium-phosphate crystals. Over time, these crystals will coat the surface of the collagen fibers to generate fully mineralized bone.

Osteoclasts
Osteoclasts are large, multinucleated cells that are of the macrophage lineage. They resorb bone by secreting organic acids, which dissolve hydroxyapatite, and lysosomal enzymes, which break down the osteoid matrix. At the bone surface, osteoclasts lie in Howship’s lacunae, surface depressions caused by the resorption of bone.

Osteoma - sclerotic lamellar bone with variable amount of medullary spaces

Cortical - 80% of skeleton
metabolism - characterized by slow turnover rate and high Young’s modulus
structure made of packed osteons or Haversian systems
osteons - outer border defined by cement lines
vascular canals contain arterioles, venules, capillaries, and nerves; if oriented along long axis of bone: Haversian canals; if oriented transversely to long axis of bone: Volkmann canals
interstitial lamellae - the region between osteons

Cancellous bone (spongy or trabecular bone)
metabolism - lower Young’s modulus and more elastic; high turnover to remodel according to stress across the bone
structure - boney struts organized into a loose network; each strut is approximately 200 micrometers in diameter; 30-90% of bone is porous and contains bone marrow; increased porosity in osteoporosis

Woven bone - immature or pathologic bone that is woven and random and is not stress oriented
compared to lamellar bone, woven bone has:
- more osteocytes per unit of volume
- higher rate of turnover
- weaker and more flexible than lamellar bone

Lamellar bone
- secondary bone created by remodeling woven bone
- organized and stress oriented
- stronger and less flexible than woven bone

Osteoid osteoma central nidus, woven bone

Osteoid osteoma woven bone

Aneurysmal bone cyst

Non ossyfying fibroma

Non ossyfying fibroma
In the lesion we can recognize that is made completely by fibroblasts, we cannot see any osteoid!

Ewing Sarcoma CD99 positive















